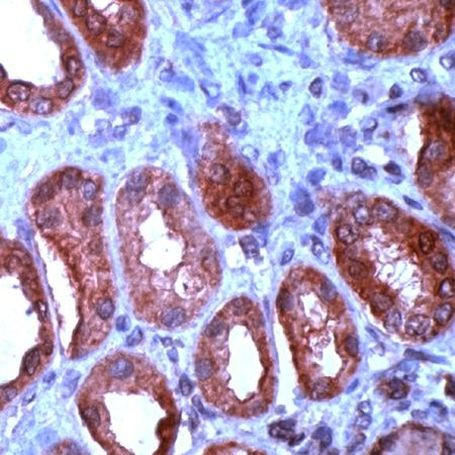
WNT1 Antibody in Immunohistochemistry (IHC)

Search
Invitrogen
WNT1 Polyclonal Antibody
{{$productOrderCtrl.translations['antibody.pdp.commerceCard.promotion.promotions']}}
{{$productOrderCtrl.translations['antibody.pdp.commerceCard.promotion.viewpromo']}}
{{$productOrderCtrl.translations['antibody.pdp.commerceCard.promotion.promocode']}}: {{promo.promoCode}} {{promo.promoTitle}} {{promo.promoDescription}}. {{$productOrderCtrl.translations['antibody.pdp.commerceCard.promotion.learnmore']}}
产品信息
PA1-38869
宿主/亚型
分类
类型
抗原
偶联物
形式
保存条件
运输条件
RRID
产品详细信息
This antibody is predicted to react with bovine, chicken, canine, amphibian, mouse and porcine based on sequence homology.
Heat-mediated antigen retrieval is recommended prior to staining, using a 10mM citrate buffer, pH 6.0, for 10 minutes followed by cooling at room temperature for 20 min. Following antigen retrieval, incubate samples with primary antibody for 30 min at room temperature. A suggested positive control is breast carcinoma.
靶标信息
Wnt proteins constitute a family of secreted glyocoproteins that activate signal transduction pathways to mediate tissue homeostasis, cell fate, cell proliferation, and self-renewal. The canonical signaling pathway is initiated upon Wnt binding to a Frizzled family receptor and an LRP5/LRP6 coreceptor, which leads to activation of the beta-catenin cascade. Non-canonical Wnt signals are activated by binding to a Frizzled family receptor and ROR2 coreceptor. Extensive research has shown that deregulation of these pathways or its components can lead to cancer. Human Wnt-1 is encoded as a 370 amino acid precursor that, upon secretion, is cleaved into a 343 amino acid (42 kDa) mature form. At the amino acid level, mature human Wnt-1 is approximately 99% identical to mature mouse Wnt-1. Depending on the tissue, Wnt-1 can activate the canonical and non-canonical signaling pathways. Studies have demonstrated its involvement in a variety of functions, including embryonic development and carcinogenesis. Wnt-1 signaling can also induce the phosphorylation and subsequent degradation of c-Myb.
仅用于科研。不用于诊断过程。未经明确授权不得转售。